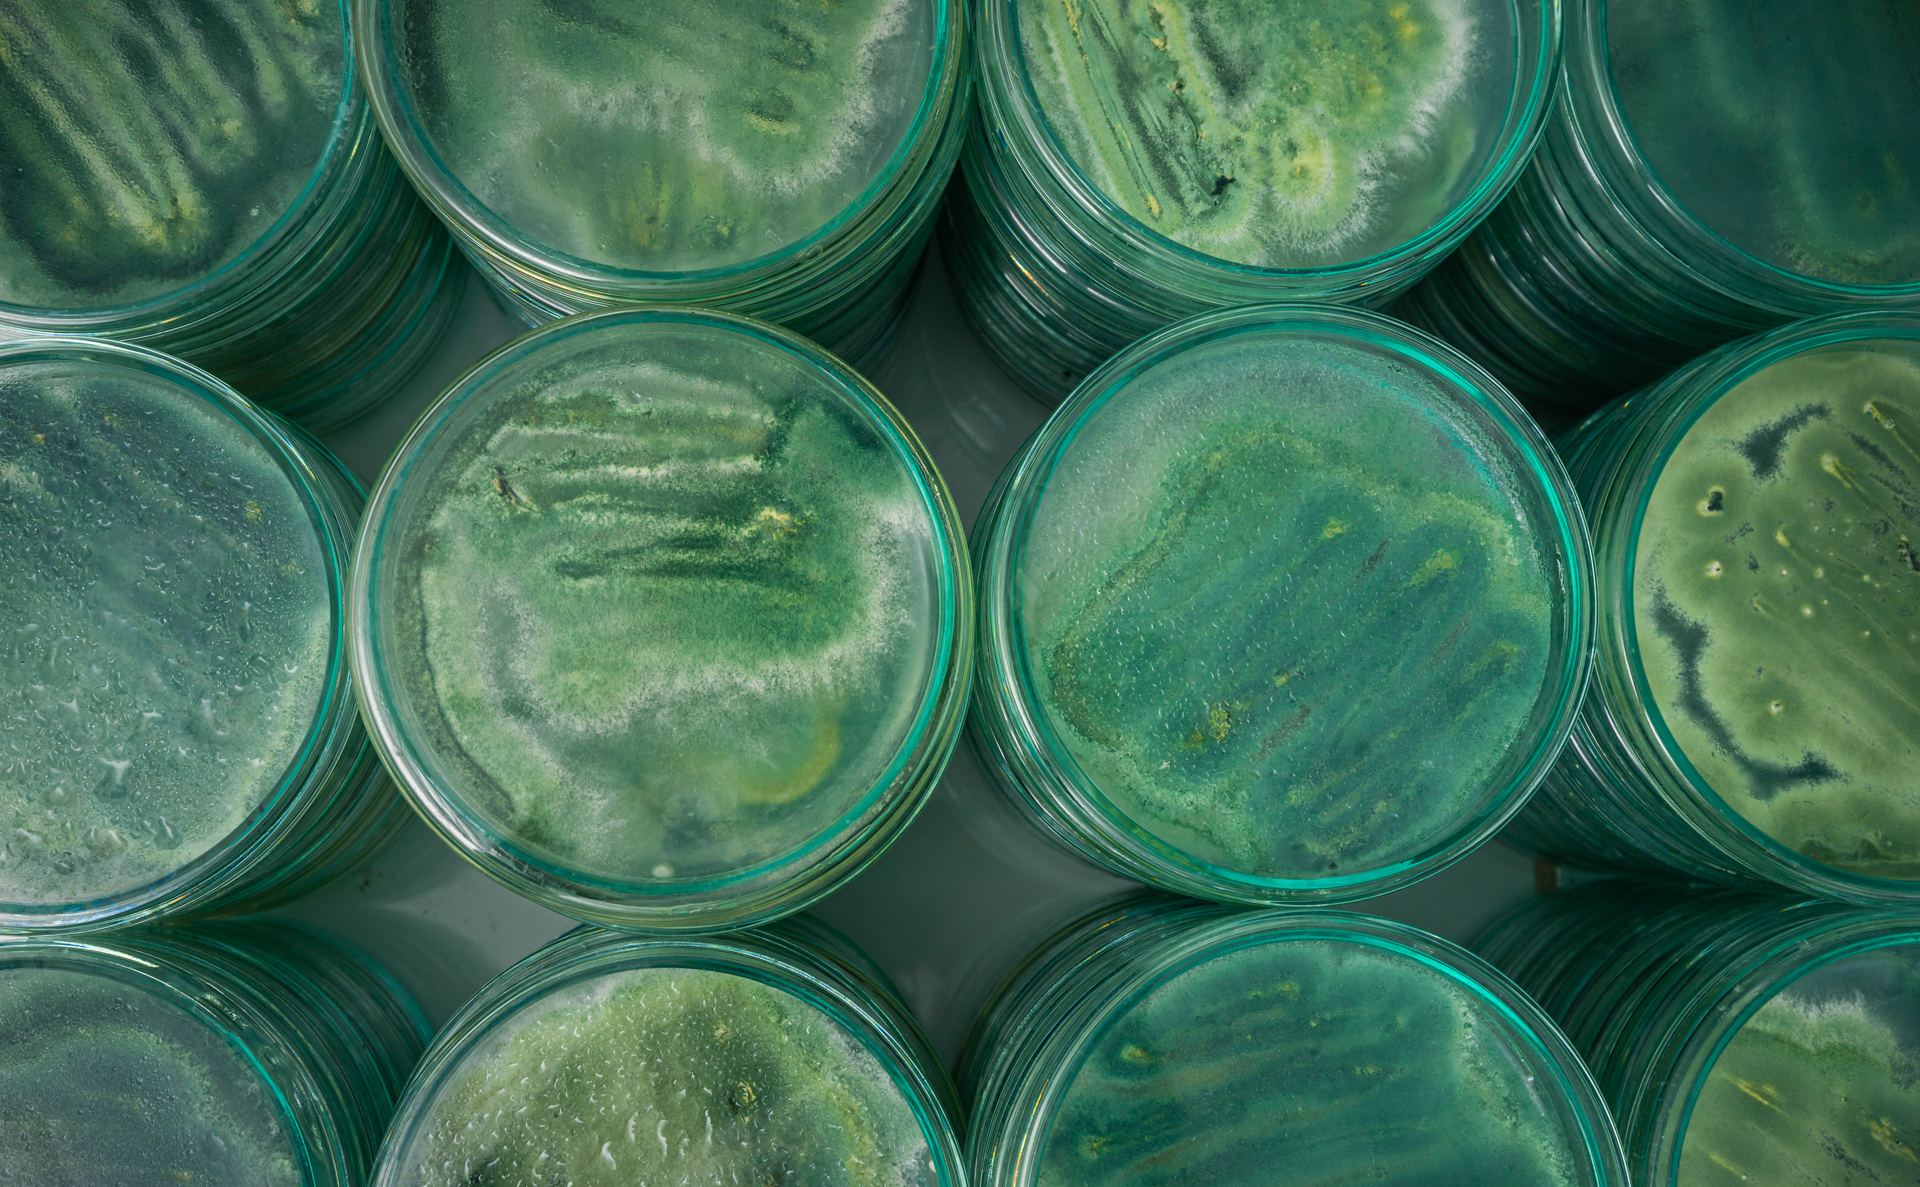
Servicio 1 - Slide 4

ASESORÍA PERSONALIZADA
Brindamos asesoría personalizada en la aplicación adecuada de productos agrícolas según el tipo de cultivo y el tipo de suelo.
MANEJO DE CULTIVO
Realizamos visitas técnicas al cultivo de nuestros clientes para garantizar el máximo rendimiento de nuestros productos.
LABORATORIO DE INVESTIGACIÓN
Contamos con un laboratorio de investigación donde desarrollamos productos agrícolas innovadores basados en estudios de campo y años de experiencia.